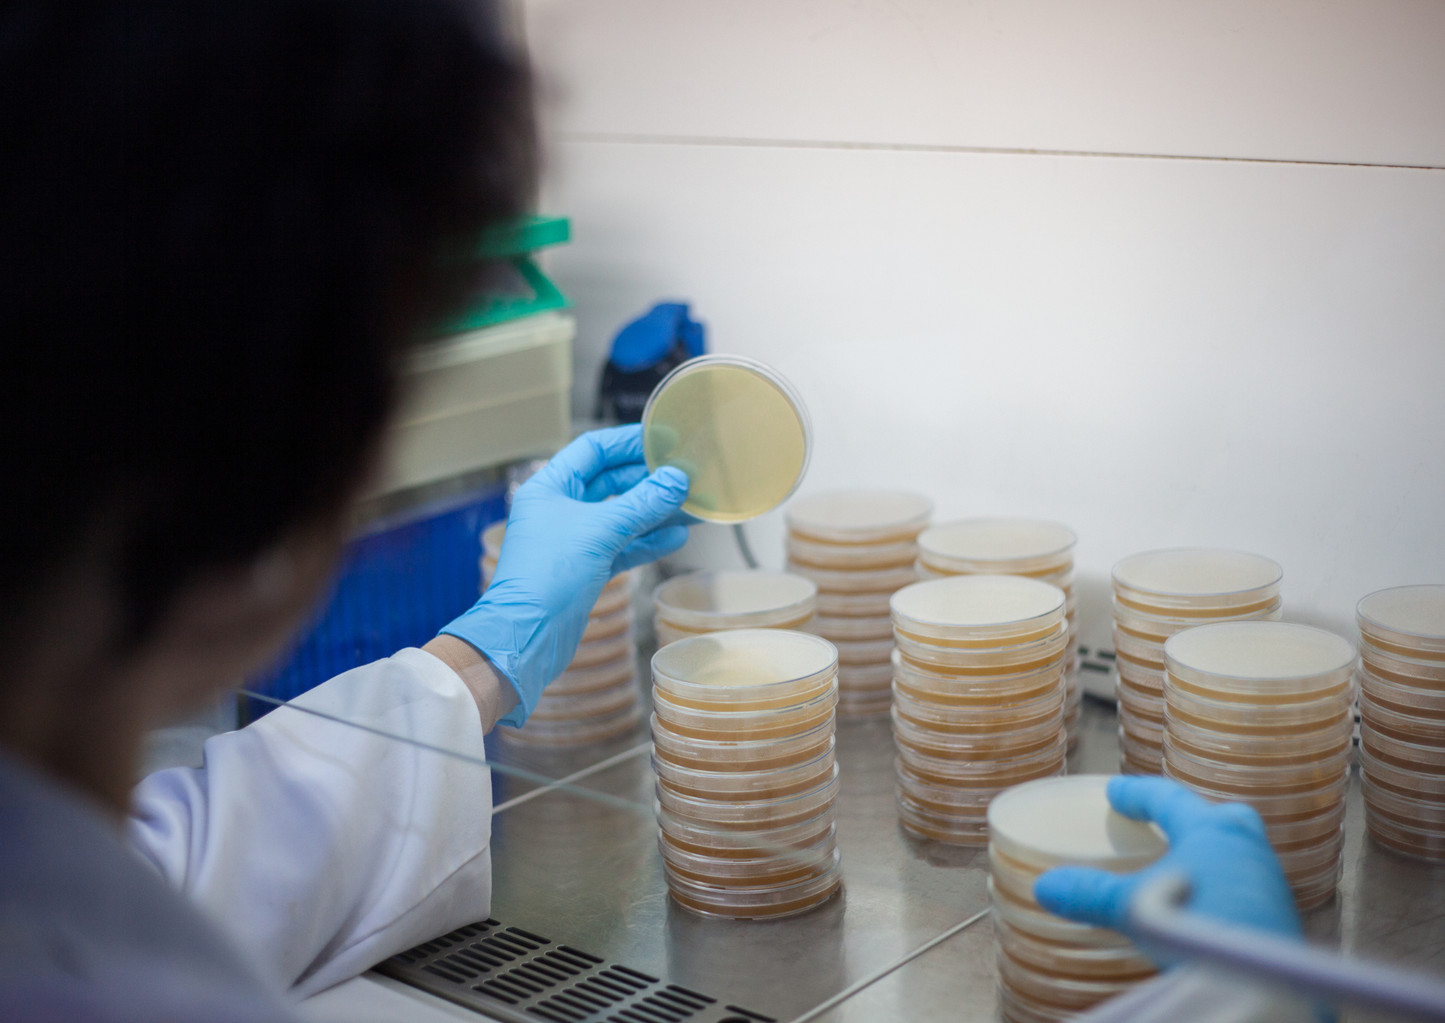

London Vet Show 2022
Thoroughly modern microbiology - bringing veterinary culture & susceptibility testing into the 21st century
Thoroughly modern microbiology - bringing veterinary culture & susceptibility testing into the 21st century
Couldn't load pickup availability
The world of clinical microbiology has made significant advances in the last decade and veterinary medicine is starting to catch up. Larger diagnostic microbiology laboratories have made investments in new technologies and methods such as MALDI-TOF and MIC testing, which enable faster, more clinically useful results to be provided to veterinarians. This session aims to introduce and explain these new technologies, discussing both their potential and limitations in respect to more traditional methods. It will give an insight into how research is pushing to use these technologies to give faster results in critically-important clinical areas. The session will focus on how the veterinary surgeon and the microbiologist can assist each other in generating robust, rapid, clinically-useful reports that support excellent antimicrobial stewardship.
- Understand the principles of MALDI-TOF identification of bacteria and fungi
- Understand how Minimum Inhibitory Concentrations (MICs) are determined, and their potential for tailored antimicrobial use
- Recognise both the improvements that new technologies bring to the diagnostic laboratory, and their limitations
- Recognise the future potential of new technologies to improve speed of reporting of clinically-critical results
Friday 18th November 2022 14:35
RVC Clinical Theatre 2
Please note this session is not RACE-approved but you can still earn a CPD certificate
Share